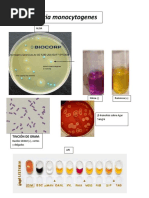

CASOS CLÍNICOS MICOLOGÍA 2
Resuelva los siguientes casos clínicos. Las preguntas que se muestran en cada saso son
una guía que puede facilitar la resolución, no se trata de responder las preguntas con
respuestas cortas. Sino que se solicita responder a manera de extenso como resolvería el
caso e incluir el algoritmo correspondiente en cada una de las preguntas. Incluya imágenes
y la bibliografía.
REQUISITOS
Elaborarlo en su libreta de apuntes
Fecha de entrega:
Lunes 3 de octubre, 15:00 h. Grupo 3
Martes 4 de octubre, 13:00 h. Grupo 2
Miércoles 5 de octubre, 12:00 h Grupo 1
1. Un paciente con diagnóstico establecido de SIDA y neumonía intersticial acude al
laboratorio para determinar el agente causal de la patología. Se toma una muestra
de esputo (flema o moco) mediante expectoración. La muestra se siembra en agar
Sabouraud. A los cinco días de realizado el cultivo se desarrolla una colonia mucoide
con aspecto de “leche condensada derramada”. ¿Cuál es el agente etiológico de la
patología? Establezca el algoritmo correcto para el diagnóstico.
2. Un paciente de 19 años previamente sano que trabaja preparando arreglos florales
refiere que usa rosas, tulipanes, claveles, girasoles y follaje con los que ha sufrido
traumatismo cutáneo en innumerables ocasiones. Se presentó en el Centro
Dermatológico por una lesión ulcerosa de fondo limpio, de borde
eritematovioláceo, indoloro, de aproximadamente 1 cm de diámetro, localizada en
dedo índice derecho. La biopsia mostró la presencia de cuerpos asteroides y el
microcultivo mostró conidióforos con conidias dispuestas en flor de margarita o
durazno. ¿Cuál es el diagnóstico para el paciente? ¿Qué algoritmo realizaría para
determinar el agente causal?
3. Paciente con antecedente de haber visitado cavernas donde abundan murciélagos
inicia cinco días después con cuadro neumónico con dificultad respiratoria,
rápidamente progresiva, hepatosplenomegalia y datos de coagulación
intravascular diseminada. ¿Cuál es el diagnóstico? ¿El agente etiológico? ¿La forma
infectante que le produjo el cuadro clínico? ¿Cuál sería la muestra para analizar y
que estructuras encontraría?
4. Paciente masculino de 34 años, con buena salud. Estuvo de visita con sus familiares
en el Navojoa Estado de Sonora durante tres semanas. Actualmente presenta
cuadro neumónico que requirió internamiento. En la biopsia de pulmón encontraron
esférulas con endosporas. ¿Cuál es el diagnóstico de este paciente, el
mecanismo de infección de esta micosis? ¿Cuáles son los exámenes de laboratorio
� de elección para el diagnóstico de esta enfermedad? ¿Cuál es el tratamiento de
elección para esta patología?
5. Paciente de 45 años, campesino, con lesión de 19 años de evolución en dorso de
pie derecho, que presenta aspecto verrugoso, zonas de atrofia y en el examen
directo aclarado con KOH, hay presencia de estructuras redondeadas septadas
de color marrón, aisladas y en racimos. ¿Cuál es el diagnóstico de la
enfermedad? ¿Cuál es el algoritmo para utilizar para en el diagnóstico del agente
etiológico?
6. Paciente de 45 años de edad ingresa al Servicio de Urgencias. Refiere cefalea de
un mes de evolución, fue tratado solamente con analgésico. Actualmente con 24
horas de evolución caracterizados por cefalea de predominio frontal constante que
no ha cedido con los analgésicos. Al cuadro se agregó vómito en proyectil y letargo.
Al examen físico se le encuentra examen de papila e hiperrreflexia generalizada. El
examen del LCR mostró estructuras redondeadas capsuladas, el citoquímico de
LCR con hipoglucorraquia, proteinorraquia y presencia de monocitos. En el medio
de Sabouraud en tubo inclinado, a los cinco días hubo desarrollo de una colonia
mucoide de color blanco cremoso con aspecto de leche condensada
derramada. ¿Cuál es el diagnóstico más probable en el paciente? ¿Cuál es el
examen de elección para realizar el diagnóstico? ¿cuál es el tratamiento de
elección?
7. Paciente de 67 años de edad con diabetes mal controlada, inició con padecimiento
actual hace nueve días, con fiebre que ha sido tratada por sus familiares con
acetaminofén. Ingresa inconsciente a Urgencias T: 38.9°C, FC: 150X, FR: 48X.
glucosa de 840 mg/dL, aliento cetónico, presenta celulitis periorbitaria con piel
color violáceo en ojo izquierdo, proptosis, quemosis ipsolateral. Cornetes inferiores
con zonas extensas de necrosis destructivas color negruzco, salida de líquido
tipo sanguinolento por ambas narinas. La TAC mostró destrucción del tercio inferior
del septum nasal y cornetes inferiores, destrucción ósea a nivel de antro maxilar
izquierdo. ¿Cuál es el diagnóstico más probable en este paciente? ¿El principal
mecanismo patógeno del agente causal es? ¿el examen de laboratorio de elección
para realizar el diagnóstico es? ¿Cuál es el tratamiento de elección?